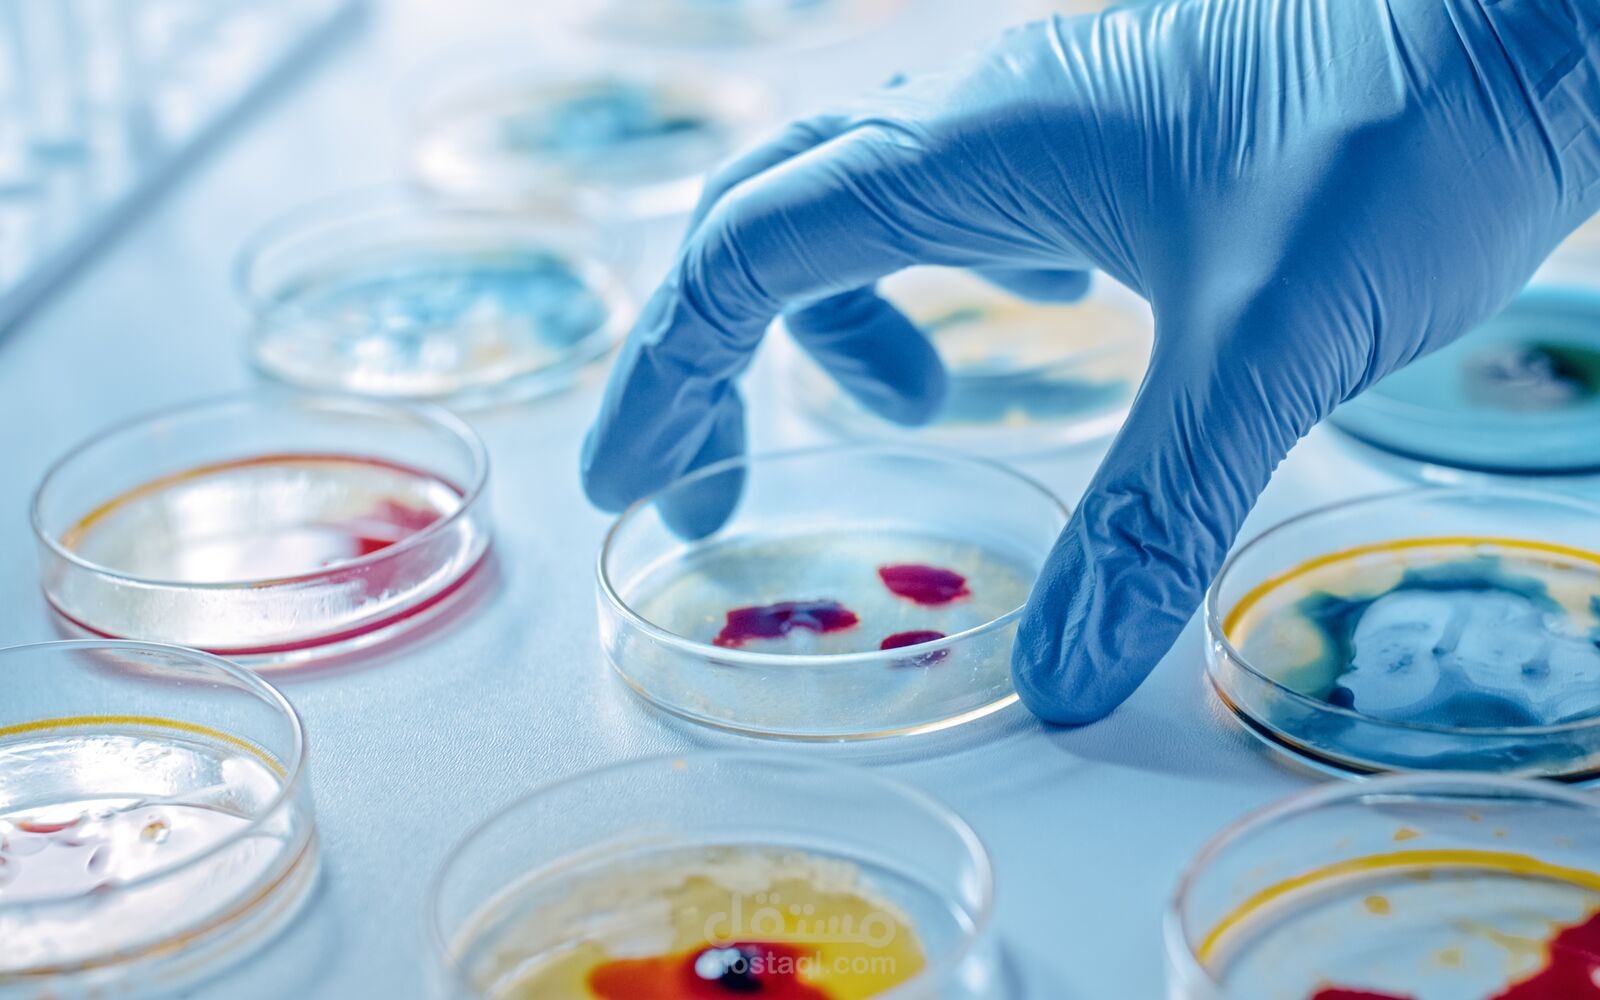
توصيه عن دراسه علم الاحياء المجهري microbiology

عمر م.
نبذة عني
السلام عليكم طالب في اخر ترم علي وجه التخرج من كليه التكنولوجيا الحيويه و قمت بكتابه بحث عليم كامل proposal و يمكنني مساعده الطلاب في كتابه ابحاث علميه و مع اضافه مصادر و citation "الاقتباس" في مجالات مثل امراض النبات , السراطانات , البيولوجيه الجزئيه , البيلولجيه الدقيقه و اخري